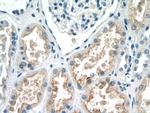
EFHD1 Antibody in Immunohistochemistry (Paraffin) (IHC (P))

Search
Proteintech
EFHD1 Polyclonal Antibody
{{$productOrderCtrl.translations['antibody.pdp.commerceCard.promotion.promotions']}}
{{$productOrderCtrl.translations['antibody.pdp.commerceCard.promotion.viewpromo']}}
{{$productOrderCtrl.translations['antibody.pdp.commerceCard.promotion.promocode']}}: {{promo.promoCode}} {{promo.promoTitle}} {{promo.promoDescription}}. {{$productOrderCtrl.translations['antibody.pdp.commerceCard.promotion.learnmore']}}
产品信息
19854-1-AP
种属反应
宿主/亚型
分类
类型
抗原
偶联物
形式
浓度
规格
纯化类型
保存液
内含物
保存条件
运输条件
产品详细信息
Immunogen sequence: MASEELACK LERRLRREEA EESGPQLAPL GAPAPEPKPE PEPPARAPTA SADAELSAQL SRRLDINEGA ARPRRCRVFN PYTEFPEFSR RLIKDLESMF KLYDAGRDGF IDLM (1-113 aa encoded by BC002449)
靶标信息
EFHD1, also known as Swiprosin-2 or SWS2, is an EF-hand and coiled-coil-containing adaptor protein identified in a subtractive hybridization study using a neuronal cell line established from the cerebellum of an adult p53-null mouse, however further study indicated no difference in normal mice. Its mRNA is widely expressed, with its expression in brain undetectable at embryonic stages, with increasing levels from postnatal to adult development. In situ hybridization showed expression in neurons but not white matter of the cerebellum and cerebrum. EHFD1 is also highly expressed in testes, ovary, and the collecting ducts of the kidney, suggesting that in non-neuronal cells, EFHD1 may be involved in gametogenesis and water-reabsorbtion.
仅用于科研。不用于诊断过程。未经明确授权不得转售。
篇参考文献 (0)
生物信息学
蛋白别名: EF-hand domain-containing protein 1; EF-hand domain-containing protein D1; Swiprosin-2; unnamed protein product
基因别名: EFHD1; MST133; MSTP133; PP3051; SWS2
UniProt ID: (Human) Q9HBQ0
Entrez Gene ID: (Human) 80303